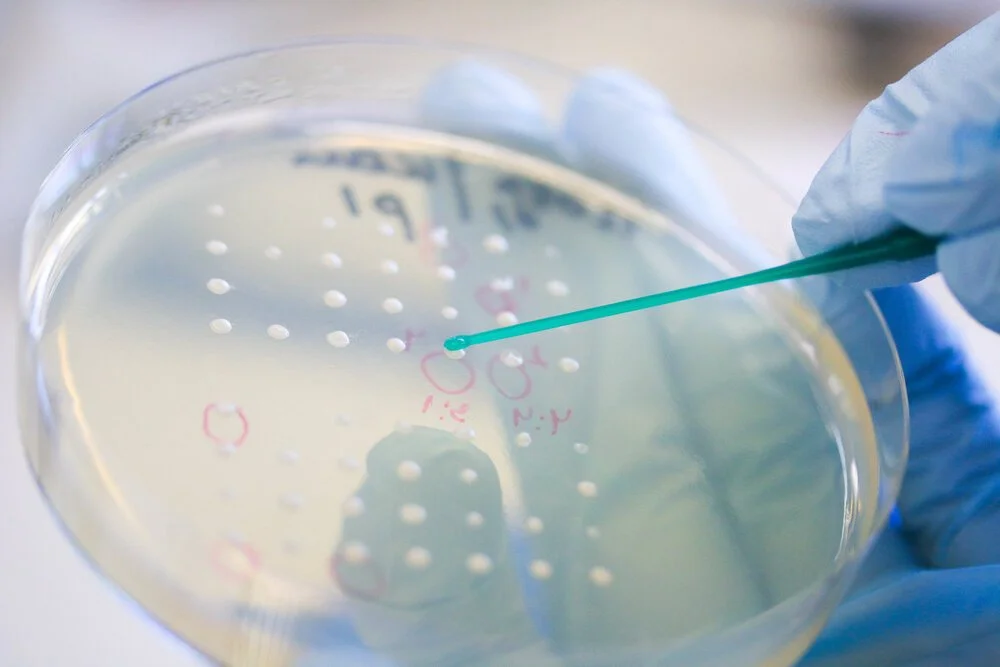

Hands at work - 2018
This work is comprised of four images, each illustrating a scientist and the object, species, concept they work to better understand. The idea behind this project is to illustrate the diversity in scientific subjects as well as to shed light on manual aspect of the scientist job. We might have the misconception from TV or films that scientists spend their day daydreaming and, while intense intellectual exercise is at the core of the scientific method, a significant portion of the scientist’s time is spent working with their hands. They are artists in their own fields.
This work was presented as an installation in [Figure 1. A.] 2018 and was voted Audience Favorite by the visitors of the exhibition.
BEFORE WINTER -
Biologists working with honey bees (Apis mellifera carnica) have to make sure the hive is healthy including that the queen is normally laying eggs. They do this once a week and it is especially important to check the well-being of the bees before winter when they will start hibernating to survive the cold temperatures.
ENTROPY -
Bio-mathematicians use equations to model diverse biological phenomenon. On the picture we can see part of an entropy computation that is here applied to model DNA strand behaviour, deepening our understanding of this complex molecule that supports life as we know it.
THE CREATION 2.0 -
Depicted here is a caterpillar from the species Pieris brassicae and it is carried on the hand by a scientist. This species can cause important damage to crops and it is, therefore, important to understand the relationship between plant and insect and how plants defend themselves against aggression by herbivores.
FOUR-BY-FOUR -
The white dots are growing colonies of fission yeast Schizosaccharomyces pombe. After the sexual cycle, S. pombe will produce four spores or offspring. Each colony originates from a single spore which was placed on the petri dish with the help of a dissector, a machine with a very small needle that can pick a single cell. Biologists use this tool to perform very thorough genetic analyses.